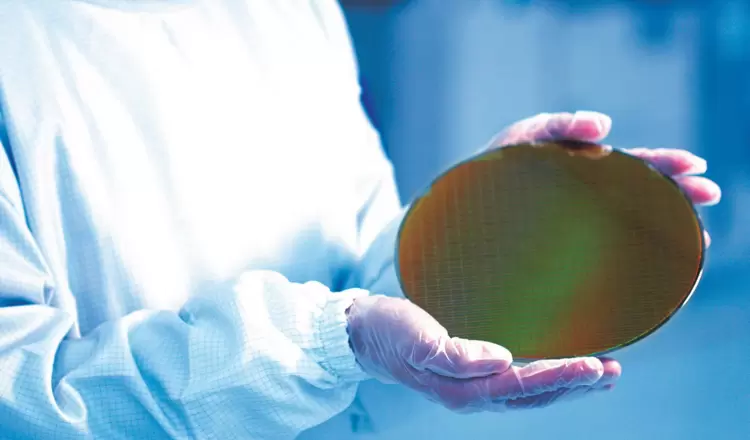
文章详情图片

(AI云资讯消息)报道显示,三星在美国的芯片业务正获得高度关注,吸引了众多无晶圆厂客户的浓厚兴趣。
自芯片制造商开始在美国大规模投资建厂以来,关于供应链层级的争论便从未停歇,即客户究竟会选择哪家作为其第二晶圆代工选项。传统上这类讨论并未引发太多关注,因为作为主要供应商的台积电始终能满足所有无晶圆厂客户的芯片需求。但随着人工智能热潮引发的严重供应链瓶颈,AMD、英伟达、高通、苹果等企业纷纷开始寻求第二供应商。据德意志银行分析,三星晶圆代工正在这场竞逐中处于领先地位。

据报道,寻求美国半导体代工服务的客户正将三星泰勒工厂作为首选,原因在于英特尔的代工执行正面临挑战。该报告指出,高通和AMD等客户计划向三星下单,很可能涉及该公司的2纳米制程SF2及其衍生技术。三星的吸引力源于晶圆代工部门已获得英伟达和苹果等客户订单,因此相较于英特尔等竞争对手,客户对三星信心更高。
近期报道披露,三星已决定优先发展泰勒工厂,将产线转向2纳米技术,并同时投资先进封装产线。目前无晶圆厂制造商正在寻找能够替代台积电N3制程的节点方案,而可供选择的技术仅有英特尔的18A和三星的SF2,而这两者在制程等级上都更具优势。美国制造商对英特尔和三星的双向倾向清晰表明,芯片产业仍有容纳更多竞争者的空间。
不过,晶圆代工订单尚未在实际产线中落地,这将是三星与英特尔作为代工厂商的下一个重要发展阶段。这两家芯片制造商正竞相争取那些寻求双重采购芯片战略的客户,因此未来竞争态势如何演变值得关注。